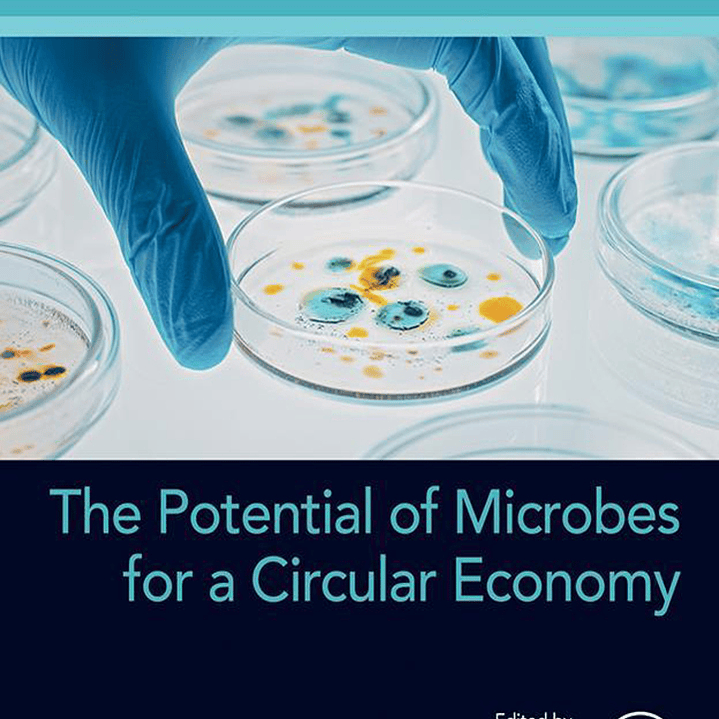

The Potential of Microbes for a Circular Economy
Description
English | 2024 | PDF | 7 MB | 313 Pages
E. K. Radhakrishnan, Jay Kumar, R. Aswani, B0CS3BS65M, 0443159246, 0443159254, 9780443159244, 978-0443159244, 978-0-443-15924-4, 978-0443159251, 978-0443159251
The Potential of Microbes for a Circular Economy provides an understanding of the role of microbes in a circular economy (CE). The book covers the development of effective bio-based formulations for field applications and describes the basic principles and applications, the important role of microorganisms, and new insights into a sustainable ecosystem for the circular economy. In addition, it compiles the latest advancement in the field of CE by covering microbes and microbial products, thus providing microbiologists the tools to engage with the public, policymakers, and industry to inform the debate on addressing current challenges.
- Provides a thorough understanding on the role of microbes in the circular economy that can help to develop effective bio-based formulations for field applications
- Describes the basic principles and applications of the Circular Economy
- Gives insights on the important role of microorganisms explored in the circular economy, which in turn provides new insights into the sustainable ecosystem